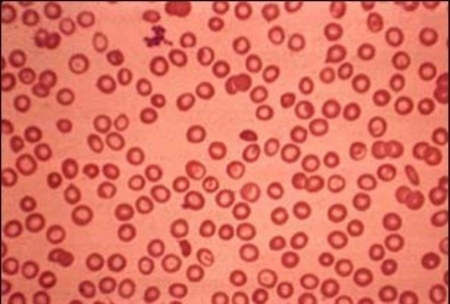
جہانیاں: بہن، بھائی تھیلیسیمیا کےمرض میں مبتلا، والدین علاج کرانے سے قاصر

جہانیاں میں دو کمسن بہن بھائی تھیلیسیمیا کے مرض میں مبتلا ہیں جن کے والدین غربت کے باعث ان کا علاج نہیں کراسکتے اور انہوں نے حکام سے مالی امداد کی اپیل کی ہے۔
جہانیاں کے گائوں چک نمبر ایک سو ستاسی ڈبلیو بی کا رہائشی اللہ دتہ کمسن بیٹی اور بیٹے کے علاج پر بیوی کے زیورات سمیت گھر کی تمام چیزیں فروخت کرکے لگا چکا ہے۔ میڈیا سے گفتگو کرتے ہوئے اللہ دتہ کا کہنا تھا کہ بچوں میں جب خون کی کمی ہوتی ہے تو سکون حاصل کرنے کے لیے پانی اور گیلی مٹی تلاش کرتے ہیں۔ لیٹنے کے لیے گیلی مٹی یا پانی نہ ملے تو زور زور سے چینح و پکار شروع کردیتے ہیں۔
ان کا کہنا تھا کہ ہر ماہ پچاس ہزار روپے خرچ کر کے بچوں کو خون لگوانے کے ساتھ ساتھ مہنگی ادویات دی جاتی ہیں۔ علاج نہ کرایا جائے تو ان کی حالت نہیں دیکھی جاتی۔ غریب محنت کش اللہ دتہ نے وزیر اعلٰی پنجاب اور مخیر حضرات سے مالی امداد کی اپیل کی ہے۔